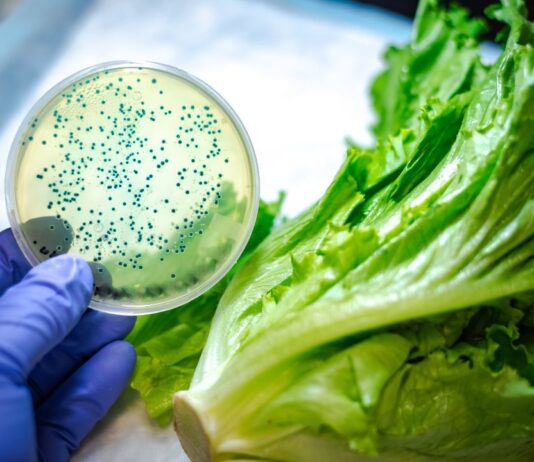
Día Mundial de la Salud: sanidad de cultivos impacta en la seguridad alimentaria Día Mundial de la Salud: sanidad de cultivos impacta en la seguridad alimentaria

AgroPress es el medio de comunicación especializado en el sector agrícola, dedicado a proporcionar información precisa y actualizada sobre las tendencias, innovaciones y desafíos que enfrentan los productores y profesionales del agro.
Redacción: [email protected]
Publicidad: [email protected]
Teléfono: +51 910 213 200